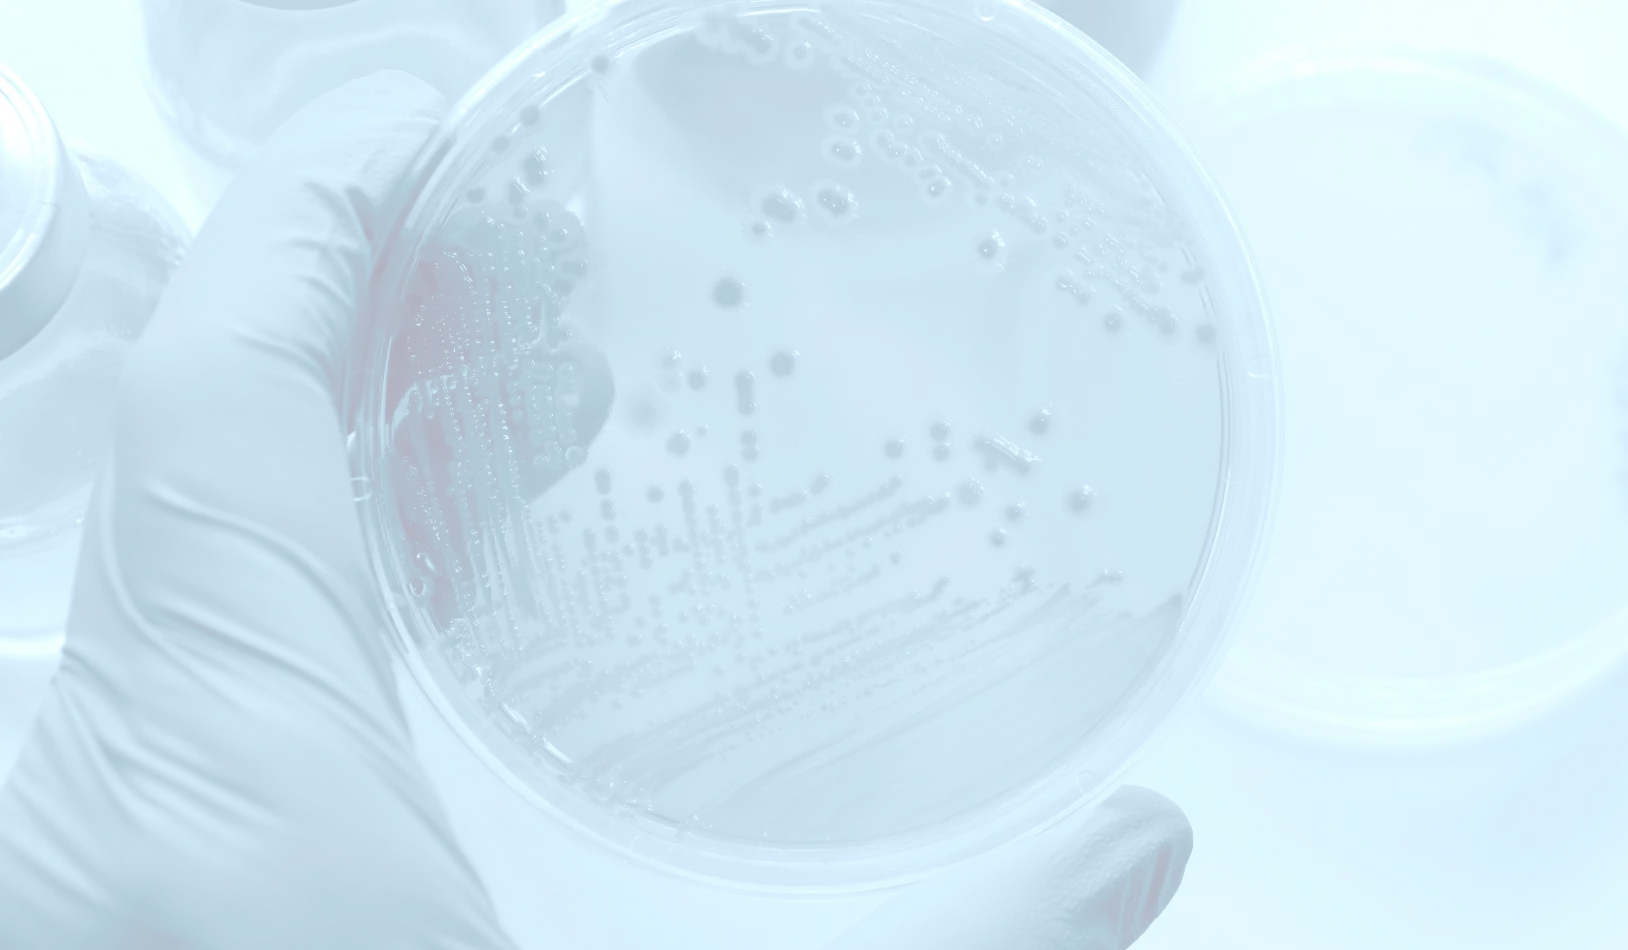
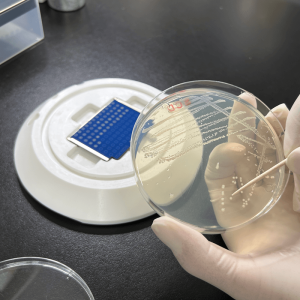
MALDI微生物同定試験（Biotyper）
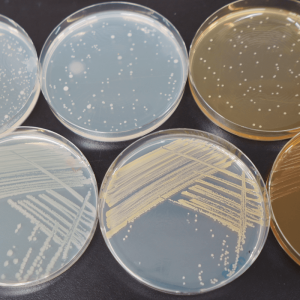
Rapid解析・カビ形態Rapid
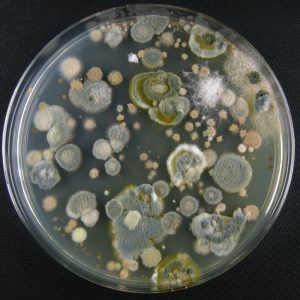
微生物分離

微生物に関する専門性、
知識と経験で、
課題解決をサポートします
研究・開発や衛生管理などの分野で当社受託試験をご利用いただいています
細菌、カビ、酵母の分類・同定、衛生管理のための迅速同定、生体や環境の群集構造解析など、
さまざまなニーズに対し、研究・開発や衛生管理の現場をサポートします。
テクノスルガ・ラボの強み
微生物専門の受託試験機関として、
確かな技術で正確な試験結果をご提供

テクノスルガ・ラボは、細菌・カビ・酵母を主体とした試験を提供する受託試験機関です。MALDI-TOF MSやDNA塩基配列解析、群集構造解析、糞便理化学分析など、高度かつ幅広い試験メニューに対応可能です。
医薬・食品メーカーから大学・公的研究機関まで、衛生管理から研究開発まで多様なニーズに応えています。論文実績やISO9001認証に裏付けられた信頼性と、専門研究者による柔軟な対応力が、私たちの強みです。
「初めての試験で不安」「試験方法を相談したい」
そんな声にも丁寧に応え、お客様のパートナーとして課題解決をサポートします。
私たちには選ばれる理由が
3つあります
-

営業訪問や学会参加により
常に情報を収集
“情報収集×お客様ニーズの理解”営業訪問や学会参加により、常にお客様や市場のニーズの把握に努めています。細菌、カビ、酵母の分類・同定、衛生管理のための迅速同定、生体や環境の群集構造解析など、さまざまなニーズにあったサービスを提供します。
-

多様な業界と研究に応える
“専門性×実績”医薬、食品、大学、研究機関など多様なクライアントに対応します。論文採用実績やISO9001、ISO17025認証など、品質の証があります。
-

はじめての方や専門外の方も安心
“丁寧なサポート × 柔軟な対応力”試験方法が分からない、検体の扱いに不安があるといったお客様にも、経験豊富な担当者が丁寧にヒアリングし、最適な試験方法をご提案します。安心してご相談いただけます。
サービス
研究・開発や衛生管理などで活用される微生物受託試験のご紹介
よくご依頼をいただくサービス
-
- MALDI微生物同定試験(Biotyper)
-
細菌もしくは酵母なら同定結果を最短即日納品/属名もしくは種名を同定/DNA塩基配列解析より迅速・安価
-
- Rapid解析・カビ形態Rapid
-
DNA塩基配列解析による微生物の迅速同定/第十八改正日本薬局方参考情報<G4-7-160>準用
-

- 生体 アンプリコンシーケンス解析
-
糞便、口腔内、皮膚など幅広い生体由来検体の微生物群集構造を解析/細菌、アーキア、カビ・酵母に対応
-

- 環境 アンプリコンシーケンス解析
-
土壌、環境水、発酵食品など幅広い環境由来検体の微生物群集構造を解析/細菌、アーキア、カビ・酵母に対応
-

- 腸内環境研究の受託サービス/糞便中有機酸(短鎖脂肪酸)分析、腸内細菌叢解析
-
糞便中有機酸(短鎖脂肪酸)分析/腸内細菌叢解析/糞便を室温保管可能な採取キット(メタボロキーパー)
-

- 腸内環境分析用 糞便採取キット・採取容器
-
糞便中の菌叢や有機酸(短鎖脂肪酸)を室温で1ヶ月間維持可能な糞便採取キット
-

- 糞便理化学分析
-
糞便中の有機酸(短鎖脂肪酸)/胆汁酸/腐敗産物/アンモニア/pH/水分/IgAの定量分析
-
- 微生物分離
-
食品、飼料、水や土壌など様々な検体から微生物を分離/目的に合わせた分離培養条件が選択可能
技術・お役立ち情報
微生物に関する技術的・学術的な情報や、
当社サービスをご利用の際に役に立つ情報をご紹介
お知らせ
テクノスルガ・ラボの最新トピックスをお届け
